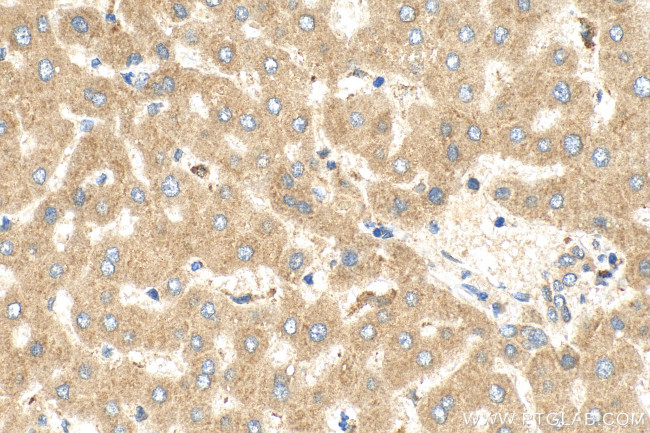
CPN2 Antibody in Immunohistochemistry (Paraffin) (IHC (P))

Search
Proteintech
CPN2 Polyclonal Antibody
{{$productOrderCtrl.translations['antibody.pdp.commerceCard.promotion.promotions']}}
{{$productOrderCtrl.translations['antibody.pdp.commerceCard.promotion.viewpromo']}}
{{$productOrderCtrl.translations['antibody.pdp.commerceCard.promotion.promocode']}}: {{promo.promoCode}} {{promo.promoTitle}} {{promo.promoDescription}}. {{$productOrderCtrl.translations['antibody.pdp.commerceCard.promotion.learnmore']}}
产品信息
27160-1-AP
种属反应
宿主/亚型
分类
类型
抗原
偶联物
形式
浓度
规格
纯化类型
保存液
内含物
保存条件
运输条件
产品详细信息
Immunogen sequence: MLPGAWLLWT SLLLLARPAQ PCPMGCDCFV QEVFCSDEEL ATVPLDIPPY TKNIIFVETS FTTLETRAFG SNPNLTKVVF LNTQLCQFRP DAFGGLPRLE DLEVTGSSFL NLSTNIFSNL TSLGKLTLNF NMLEALPEGL FQHLAALESL HLQGNQLQAL PRRLFQPLTH LKTLNLAQNL
靶标信息
CPN2, the 83 kDa subunit binds and stabilizes the catalytic subunit at 37 degrees Celsius and keeps it in circulation. Under some circumstances it may be an allosteric modifier of the catalytic subunit.
仅用于科研。不用于诊断过程。未经明确授权不得转售。
篇参考文献 (0)
生物信息学
蛋白别名: Carboxypeptidase N 83 kDa chain; Carboxypeptidase N large subunit; Carboxypeptidase N polypeptide 2; Carboxypeptidase N regulatory subunit; Carboxypeptidase N subunit 2; carboxypeptidase N, polypeptide 2, 83kD; CPN reg; CPN-reg; CPNreg
基因别名: ACBP; CPN2
UniProt ID: (Human) P22792
Entrez Gene ID: (Human) 1370